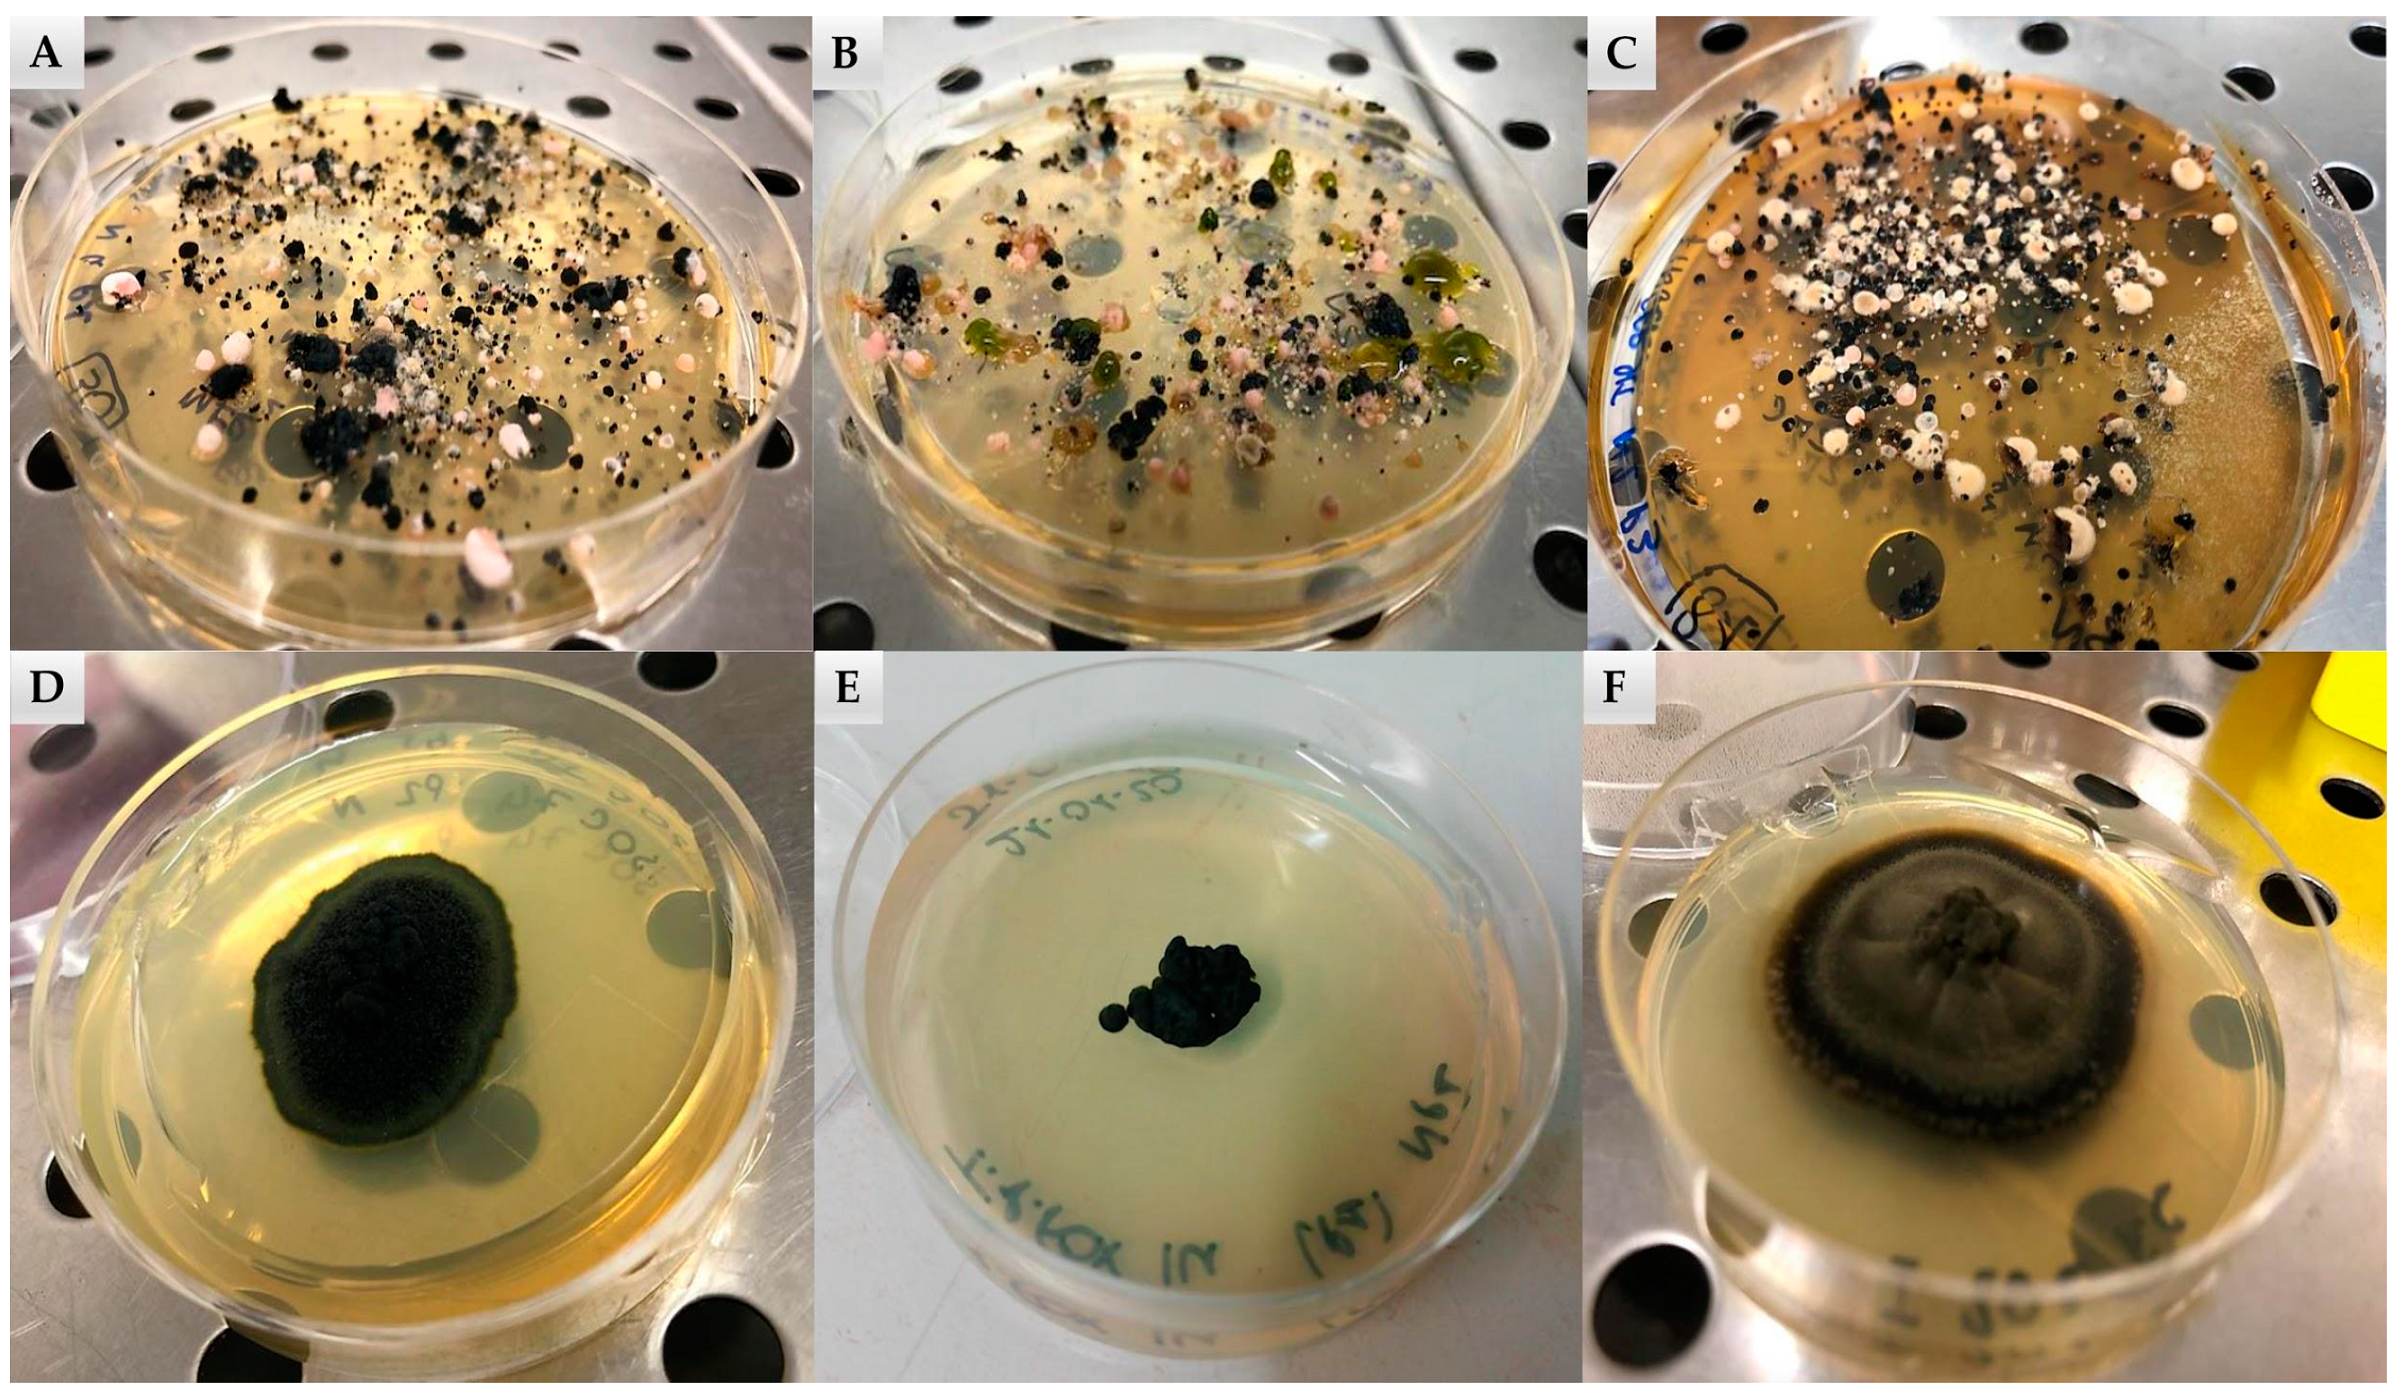
Jof 07 00213 g002 Jof 07 00213 g002

Culture-Dependent and Amplicon Sequencing Approaches Reveal Diversity and Distribution of Black Fungi in Antarctic Cryptoendolithic Communities
Abstract
1. Introduction
2. Materials and Methods
2.1. Sampling Area
2.2. Isolation and Identification of Culturable Fungi
2.3. Identification of Fungal Strains
2.4. DNA Extraction and Metabarcoding Sequencing
2.5. Bioinformatics Analysis and Downstream Analysis
3. Results
3.1. Occurrence of Black Fungi in the Antarctic Endolithic Communities through Culture-Dependent Approach and Amplicon Sequencing
3.2. Effect of Sun Exposure
3.3. Effects of Altitude on Black Fungi Relative Abundance
4. Discussion
5. Conclusions
Supplementary Materials
Author Contributions
Funding
Institutional Review Board Statement
Informed Consent Statement
Data Availability Statement
Acknowledgments
Conflicts of Interest
References
- Friedmann, E.I.; Ocampo, R. Endolithic blue-green algae in dry valleys-primary producers in Antarcticdesert ecosystem. Science 1976, 193, 1247–1249. [Google Scholar] [CrossRef] [PubMed]
- Friedmann, E.I. Endolithic Microorganisms in the Antarctic Cold Desert. Science 1982, 215, 1045–1053. [Google Scholar] [CrossRef] [PubMed]
- Walker, J.; Pace, N.R. Phylogenetic Composition of Rocky Mountain Endolithic Microbial Ecosystems. Appl. Environ. Microbiol. 2007, 73, 3497–3504. [Google Scholar] [CrossRef] [PubMed]
- Chan, Y.; Lacap, D.C.; Lau, M.C.; Ha, K.Y.; Warren-Rhodes, K.A.; Cockell, C.S.; Cowan, D.A.; McKay, C.P.; Pointing, S.B. Hypolithic microbial communities: Between a rock and a hard place. Environ. Microbiol. 2012, 14, 2272–2282. [Google Scholar] [CrossRef] [PubMed]
- Zucconi, L.; Onofri, S.; Cecchini, C.; Isola, D.; Ripa, C.; Fenice, M.; Madonna, S.; Reboleiro-Rivas, P.; Selbmann, L. Mapping the lithic colonization at the boundaries of life in Northern Victoria Land, Antarctica. Polar Biol. 2016, 39, 91–102. [Google Scholar] [CrossRef]
- Selbmann, L.; Onofri, S.; Coleine, C.; Buzzini, P.; Canini, F.; Zucconi, L. Effect of environmental parameters on biodiversity of the fungal component in the lithic Antarctic communities. Extremophiles 2017, 21, 1069–1080. [Google Scholar] [CrossRef]
- Selbmann, L.; de Hoog, G.S.; Mazzaglia, A.; Friedmann, E.I.; Onofri, S. Fungi at the edge of life: Cryptoendolithic black fungi from Antarctic desert. Stud. Mycol. 2005, 51, 1–32. [Google Scholar]
- Selbmann, L.; Egidi, E.; Isola, D.; Onofri, S.; Zucconi, L.; de Hoog, G.S.; Lantieri, A. Biodiversity, evolution and adaptation of fungi in extreme environments. Plant Biosyst. 2013, 147, 237–246. [Google Scholar] [CrossRef]
- Harutyunyan, S.; Muggia, L.; Grube, M. Black fungi in lichens from seasonally arid habitats. Stud. Mycol. 2008, 61, 83–90. [Google Scholar] [CrossRef]
- Selbmann, L.; Isola, D.; Egidi, E.; Zucconi, L.; Gueidan, C.; De Hoog, G.S.; Onofri, S. Mountain tips as reservoirs for new rock-fungal entities: Saxomyces gen. nov. and four new species from the Alps. Fungal Divers. 2014, 65, 167–182. [Google Scholar] [CrossRef]
- Pacelli, C.; Selbmann, L.; Zucconi, L.; Coleine, C.; De Vera, J.-P.; Rabbow, E.; Böttger, U.; Dadachova, E.; Onofri, S. Responses of the Black Fungus Cryomyces antarcticus to Simulated Mars and Space Conditions on Rock Analogs. Astrobiology 2019, 19, 209–220. [Google Scholar] [CrossRef] [PubMed]
- Onofri, S.; Selbmann, L.; Pacelli, C.; Zucconi, L.; Rabbow, E.; De Vera, J.-P. Survival, DNA, and Ultrastructural Integrity of a Cryptoendolithic Antarctic Fungus in Mars and Lunar Rock Analogs Exposed Outside the International Space Station. Astrobiology 2019, 19, 170–182. [Google Scholar] [CrossRef] [PubMed]
- Ruibal, C.; Gonzalo, P.; Bills, G.F. Isolation and characterization of melanized fungi from limestone formations in Mallorca. Mycol. Prog. 2005, 4, 23–38. [Google Scholar] [CrossRef]
- Sert, H.B.; Sümbül, H.; Sterflinger, K. Microcolonial fungi from antique marbles in Perge/Side/Termessos (Antalya/Turkey). Antonie Leeuwenhoek 2007, 91, 217–227. [Google Scholar] [CrossRef] [PubMed]
- Selbmann, L.; de Hoog, G.S.; Zucconi, L.; Isola, D.; Ruisi, S.; van den Ende, A.G.; Ruibal, C.; De Leo, F.; Urzì, C.; Onofri, S. Drought meets acid: Three new genera in a dothidealean clade of extremotolerant fungi. Stud. Mycol. 2008, 61, 1–20. [Google Scholar] [CrossRef]
- Egidi, E.; De Hoog, G.S.; Isola, D.; Onofri, S.; Quaedvlieg, W.; De Vries, M.; Verkley, G.J.M.; Stielow, J.B.; Zucconi, L.; Selbmann, L. Phylogeny and taxonomy of meristematic rock-inhabiting black fungi in the Dothideomycetes based on multi-locus phylogenies. Fungal Divers. 2014, 65, 127–165. [Google Scholar] [CrossRef]
- Isola, D.; Zucconi, L.; Onofri, S.; Caneva, G.; De Hoog, G.S.; Selbmann, L. Extremotolerant rock inhabiting black fungi from Italian monumental sites. Fungal Divers. 2016, 76, 75–96. [Google Scholar] [CrossRef]
- Onofri, S.; De La Torre, R.; De Vera, J.-P.; Ott, S.; Zucconi, L.; Selbmann, L.; Scalzi, G.; Venkateswaran, K.J.; Rabbow, E.; Sanchez Inigo, F.J.; et al. Survival of Rock-Colonizing Organisms after 1.5 Years in Outer Space. Astrobiology 2012, 12, 508–516. [Google Scholar] [CrossRef]
- Onofri, S.; De Vera, J.-P.; Zucconi, L.; Selbmann, L.; Scalzi, G.; Venkateswaran, K.J.; Rabbow, E.; De La Torre, R.; Horneck, G. Survival of Antarctic Cryptoendolithic Fungi in Simulated Martian Conditions on Board the International Space Station. Astrobiology 2015, 15, 1052–1059. [Google Scholar] [CrossRef]
- Archer, S.D.J.M.; de los Rios, A.; Lee, K.C.; Niederberger, T.S.; Cary, S.C.; Coyne, J.K.; Douglas, S.; Lacap-Bugler, D.C.; Pointing, S.B. Endolithic microbial diversity in sandstone and granite from the McMurdo Dry Valleys, Antarctica. Polar Biol. 2017, 40, 997–1006. [Google Scholar] [CrossRef]
- Coleine, C.; Stajich, J.E.; Zucconi, L.; Onofri, S.; Pombubpa, N.; Egidi, E.; Franks, A.; Buzzini, P.; Selbmann, L. Antarctic Cryptoendolithic Fungal Communities Are Highly Adapted and Dominated by Lecanoromycetes and Dothideomycetes. Front. Microbiol. 2018, 9, 1392. [Google Scholar] [CrossRef] [PubMed]
- Coleine, C.; Zucconi, L.; Onofri, S.; Pombubpa, N.; Stajich, J.E.; Selbmann, L. Sun exposure shapes functional grouping of fungi cryptoendolithic Antarctic communities. Life 2018, 8, 19. [Google Scholar] [CrossRef] [PubMed]
- Coleine, C.; Pombubpa, N.; Zucconi, L.; Onofri, S.; Stajich, J.E.; Selbmann, L. Endolithic Fungal Species Markers for Harshest Conditions in the McMurdo Dry Valleys, Antarctica. Life 2020, 10, 13. [Google Scholar] [CrossRef] [PubMed]
- Friedmann, E.I. Microorganisms in Antarctic desert rocks from dry valleys and Dufek Massif. Antarctic. J. US 1977, 12, 26–29. [Google Scholar]
- Nowrotek, M.; Jałowiecki, L.; Harnisz, M.; Grażyna, A.P. Culturomics and metagenomics: In understanding of environmental resistome. Front. Environ. Sci. Eng. 2019, 13, 40. [Google Scholar] [CrossRef]
- Perini, L.; Gostinčar, C.; Gunde-Cimerman, N. Fungal and bacterial diversity of Svalbard subglacial ice. Sci. Rep. 2019, 9, 1–15. [Google Scholar] [CrossRef]
- Smith, D.P.; Peay, K.G. Sequence Depth, Not PCR Replication, Improves Ecological Inference from Next Generation DNA Sequencing. PLoS ONE 2014, 9, e90234. [Google Scholar] [CrossRef]
- Palmer, J.M.; Jusino, M.A.; Banik, M.T.; Lindner, D.L. Non-biological synthetic spike-in controls and the AMPtk software pipeline improve mycobiome data. PeerJ 2018, 6, e4925. [Google Scholar] [CrossRef] [PubMed]
- Edgar, R.C. Search and clustering orders of magnitude faster than BLAST. Bioinformatics 2010, 26, 2460–2461. [Google Scholar] [CrossRef]
- Lindahl, B.D.; Nilsson, R.H.; Tedersoo, L.; Abarenkov, K.; Carlsen, T.; Kjøller, R.; Kõljalg, U.; Pennanen, T.; Rosendahl, S.; Stenlid, J.; et al. Fungal community analysis by high-throughput sequencing of amplified markers-a user’s guide. New Phytol. 2013, 199, 288–299. [Google Scholar] [CrossRef]
- Khan, A.; Mathelier, A. Intervene: A tool for intersection and visualization of multiple gene or genomic region sets. BMC Bioinform. 2017, 18, 287. [Google Scholar] [CrossRef] [PubMed]
- Oliveros, J.C. VENNY. An Interactive Tool for Comparing Lists with Venn Diagrams. 2007. Available online: http://bioinfogp.cnb.csic.es/tools/venny/index.html (accessed on 20 November 2013).
- Albanese, D.; Riccadonna, S.; Donati, C.; Franceschi, P. A practical tool for maximal information coefficient analysis. GigaScience 2018, 7, 1–8. [Google Scholar] [CrossRef]
- Reshef, D.N.; Reshef, Y.A.; Finucane, H.K.; Grossman, S.R.; McVean, G.; Turnbaugh, P.J.; Lander, E.S.; Mitzenmacher, M.; Sabeti, P.C. Detecting Novel Associations in Large Data Sets. Science 2011, 334, 1518–1524. [Google Scholar] [CrossRef] [PubMed]
- Zhang, X.Y.; Tang, G.L.; Xu, X.Y.; Nong, X.H.; Qi, S.H. Insights into Deep-Sea Sediment Fungal Communities from the East Indian Ocean Using Targeted Environmental Sequencing Combined with Traditional Cultivation. PLoS ONE 2014, 9, e109118. [Google Scholar] [CrossRef] [PubMed]
- Shinohara, N.; Woo, C.; Yamamoto, N.; Hashimoto, K.; Yoshida-Ohuchi, H.; Kawakami, Y. Comparison of DNA sequencing and morphological identification techniques to characterize environmental fungal communities. Sci. Rep. 2021, 11, 1–8. [Google Scholar] [CrossRef] [PubMed]
- Onofri, S.; Selbmann, L.; Zucconi, L.; de Hoog, G.S.; de los Rios, A.; Ruisi, S.; Grube, M. Fungal associations at the cold edge of life. In Algae and Cyanobacteria in Extreme Environments; Springer: Dordrecht, The Netherlands, 2007; pp. 735–757. [Google Scholar]
- De los Rios, A.; Wierzchos, J.; Ascaso, C. The lithic microbial ecosystems of Antarctica’s McMurdo Dry Valleys. Antarct. Sci. 2014, 26, 459–477. [Google Scholar] [CrossRef][Green Version]
- Perez-Ortega, S.; Ortiz-Alvarez, R.; Allan Green, T.G.; de los Rios, A. Lichen myco- and photobiont diversity and their relationships at the edge of life (McMurdo Dry Valleys, Antarctica). FEMS Microbiol. Ecol. 2012, 82, 429–448. [Google Scholar] [CrossRef]
- Selbmann, L.; Zucconi, L.; Onofri, S.; Cecchini, C.; Isola, D.; Turchetti, B.; Buzzini, P. Taxonomic and phenotypic characterization of yeasts isolated from worldwide cold rock-associated habitats. Fungal Biol. 2014, 118, 61–71. [Google Scholar] [CrossRef]
- Coleine, C.; Stajich, J.E.; de Los Ríos, A.; Selbmann, L. Beyond the extremes: Rocks as ultimate refuge for fungi in drylands. Mycologia 2021, 113, 108–133. [Google Scholar] [CrossRef]
- Selbmann, L.; Pacelli, C.; Zucconi, L.; Dadachova, E.; Moeller, R.; De Vera, J.P.; Onofri, S. Resistance of an Antarctic cryptoendolithic black fungus to radiation gives new insights of astrobiological relevance. Fungal Biol. 2018, 122, 546–554. [Google Scholar] [CrossRef]
- Aureli, L.; Pacelli, C.; Cassaro, A.; Fujimori, A.; Moeller, R.; Onofri, S. Iron Ion Particle Radiation Resistance of Dried Colonies of Cryomyces antarcticus Embedded in Martian Regolith Analogues. Life 2020, 10, 306. [Google Scholar] [CrossRef]
- Coleine, C.; Masonjones, S.; Sterflinger, K.; Onofri, S.; Selbmann, L.; Stajich, J.E. Peculiar genomic traits in the stress-adapted cryptoendolithic Antarctic fungus Friedmanniomyces endolithicus. Fungal Biol. 2020, 124, 458–467. [Google Scholar] [CrossRef] [PubMed]
- Porteous, N.B.; Grooters, A.M.; Redding, S.W.; Thompson, E.H.; Rinaldi, M.G.; De Hoog, G.S.; Sutton, D.A. Identification of Exophiala mesophila Isolated from Treated Dental Unit Waterlines. J. Clin. Microbiol. 2003, 41, 3885–3889. [Google Scholar] [CrossRef] [PubMed]
- Gostinčar, C.; Zajc, J.; Lenassi, M.; Plemenitaš, A.; De Hoog, S.; Al-Hatmi, A.M.; Gunde-Cimerman, N. Fungi between extremotolerance and opportunistic pathogenicity on humans. Fungal Divers. 2018, 93, 195–213. [Google Scholar] [CrossRef]
- Branda, E.; Turchetti, B.; Diolaiuti, G.; Pecci, M.; Smiraglia, C.; Buzzini, P. Yeast and yeast-like diversity in the southernmost glacier of Europe (Calderone Glacier, Apennines, Italy). FEMS Microbiol. Ecol. 2010, 72, 354–369. [Google Scholar] [CrossRef]
- Coleine, C.; Selbmann, L.; Masonjones, S.; Onofri, S.; Zucconi, L.; Stajich, J.E. Draft Genome Sequence of an Antarctic Isolate of the Black Yeast Fungus Exophiala mesophila. Microbiol. Resour. Announc. 2019, 8, e00142-19. [Google Scholar] [CrossRef]
- Coleine, C.; Pombubpa, N.; Zucconi, L.; Onofri, S.; Turchetti, B.; Buzzini, P.; Selbmann, L. Uncovered Microbial Diversity in Antarctic Cryptoendolithic Communities Sampling three Representative Locations of the Victoria Land. Microorganisms 2020, 8, 942. [Google Scholar] [CrossRef]
- Coleine, C.; Stajich, J.E.; Pombubpa, N.; Zucconi, L.; Onofri, S.; Selbmann, L. Sampling strategies to assess microbial diversity of Antarctic cryptoendolithic communities. Polar Biol. 2020, 43, 225–235. [Google Scholar] [CrossRef]
- Coleine, C.; Gevi, F.; Fanelli, G.; Onofri, S.; Timperio, A.M.; Selbmann, L. Specific adaptations are selected in opposite sun exposed Antarctic cryptoendolithic communities as revealed by untargeted metabolomics. PLoS ONE 2020, 15, e0233805. [Google Scholar] [CrossRef]
- Coleine, C.; Stajich, J.E.; Pombubpa, N.; Zucconi, L.; Onofri, S.; Canini, F.; Selbmann, L. Altitude and fungal diversity influence the structure of Antarctic cryptoendolithic Bacteria communities. Environ. Microbiol. Rep. 2019, 11, 718–726. [Google Scholar] [CrossRef]

Publisher’s Note: MDPI stays neutral with regard to jurisdictional claims in published maps and institutional affiliations. |
© 2021 by the authors. Licensee MDPI, Basel, Switzerland. This article is an open access article distributed under the terms and conditions of the Creative Commons Attribution (CC BY) license (http://creativecommons.org/licenses/by/4.0/).
Share and Cite
Selbmann, L.; Stoppiello, G.A.; Onofri, S.; Stajich, J.E.; Coleine, C. Culture-Dependent and Amplicon Sequencing Approaches Reveal Diversity and Distribution of Black Fungi in Antarctic Cryptoendolithic Communities. J. Fungi 2021, 7, 213. https://doi.org/10.3390/jof7030213
Selbmann L, Stoppiello GA, Onofri S, Stajich JE, Coleine C. Culture-Dependent and Amplicon Sequencing Approaches Reveal Diversity and Distribution of Black Fungi in Antarctic Cryptoendolithic Communities. Journal of Fungi. 2021; 7(3):213. https://doi.org/10.3390/jof7030213
Chicago/Turabian StyleSelbmann, Laura, Gerardo A. Stoppiello, Silvano Onofri, Jason E. Stajich, and Claudia Coleine. 2021. "Culture-Dependent and Amplicon Sequencing Approaches Reveal Diversity and Distribution of Black Fungi in Antarctic Cryptoendolithic Communities" Journal of Fungi 7, no. 3: 213. https://doi.org/10.3390/jof7030213
APA StyleSelbmann, L., Stoppiello, G. A., Onofri, S., Stajich, J. E., & Coleine, C. (2021). Culture-Dependent and Amplicon Sequencing Approaches Reveal Diversity and Distribution of Black Fungi in Antarctic Cryptoendolithic Communities. Journal of Fungi, 7(3), 213. https://doi.org/10.3390/jof7030213

